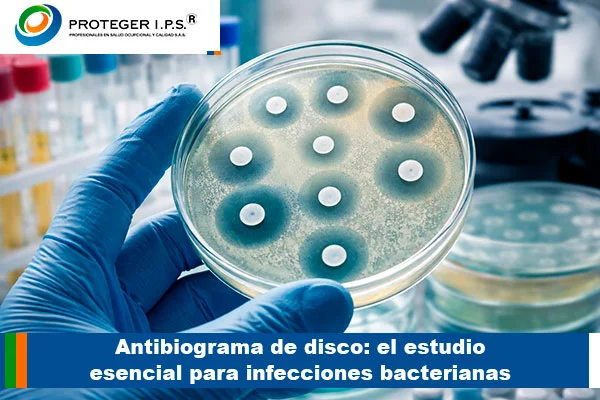
antibiograma de disco

Antibiograma de disco: el estudio esencial para infecciones bacterianas
El antibiograma de disco es una prueba fundamental en el diagnóstico de infecciones bacterianas, ya que permite identificar qué antibiótico es más efectivo para cada paciente. Comprender cómo funciona el antibiograma de disco, cuándo se solicita y por qué es tan importante, ayuda a mejorar los tratamientos médicos y a combatir la resistencia bacteriana de forma responsable y oportuna.
¿Qué es el antibiograma de disco y para qué sirve?
¿Sabes cómo el antibiograma de disco permite elegir el antibiótico correcto y mejorar el tratamiento de una infección?
¿Alguna vez te has preguntado cómo los médicos saben qué antibiótico realmente funciona frente a una bacteria? El antibiograma de disco es una prueba de laboratorio esencial que permite determinar la sensibilidad o resistencia de una bacteria frente a diferentes antibióticos. Gracias al antibiograma de disco, los profesionales de la salud pueden tomar decisiones más precisas, seguras y efectivas en el tratamiento de infecciones bacterianas.
El antibiograma de disco consiste en un estudio microbiológico que se realiza a partir de una muestra clínica, como orina, sangre, secreciones o tejidos. En el laboratorio, la bacteria aislada se expone a discos impregnados con antibióticos específicos, lo que permite observar su comportamiento. Este procedimiento convierte al antibiograma de disco en una herramienta clave para identificar qué medicamento es realmente eficaz y cuál no debe utilizarse.
La principal función del antibiograma de disco es guiar el tratamiento antibiótico de manera adecuada, evitando el uso innecesario de medicamentos que no generan efecto. Cuando se utiliza el antibiograma de disco, se reduce el riesgo de resistencia bacteriana, se mejora la evolución del paciente y se optimiza el tiempo de recuperación, especialmente en infecciones persistentes o recurrentes.
Además, el antibiograma de disco es ampliamente utilizado en hospitales, clínicas y laboratorios clínicos debido a su confiabilidad y accesibilidad. Esta prueba permite al médico contar con información clara sobre la respuesta de la bacteria frente a múltiples antibióticos, haciendo del antibiograma de disco una base sólida para un diagnóstico certero y un tratamiento personalizado.
En términos de salud pública, el antibiograma de disco cumple un rol fundamental en la vigilancia de la resistencia bacteriana. Al conocer los patrones de sensibilidad, el antibiograma de disco ayuda a controlar el uso indiscriminado de antibióticos y a promover prácticas médicas más responsables, protegiendo tanto al paciente como a la comunidad en general.
¿Cómo funciona el antibiograma de disco?
¿Te has preguntado qué ocurre en el laboratorio durante un antibiograma de disco y cómo se obtienen resultados confiables?
¿Cómo se logra saber con exactitud si una bacteria es sensible o resistente a un antibiótico? El antibiograma de disco funciona mediante un procedimiento microbiológico controlado que permite observar la reacción de una bacteria frente a distintos antibióticos. Gracias al antibiograma de disco, los laboratorios pueden ofrecer resultados claros que orientan el tratamiento médico de manera segura y eficaz.
El proceso del antibiograma de disco inicia cuando la muestra clínica del paciente es cultivada en un medio especial que favorece el crecimiento bacteriano. Una vez aislada la bacteria, se colocan discos impregnados con antibióticos específicos sobre la superficie del cultivo. Este paso es fundamental, ya que el antibiograma de disco evalúa cómo la bacteria responde al contacto directo con cada medicamento.
Durante el tiempo de incubación, el antibiograma de disco permite observar la formación de zonas claras alrededor de los discos, conocidas como halos de inhibición. Estos halos indican qué tan efectivo es cada antibiótico frente a la bacteria analizada. Cuanto mayor es el halo, mayor es la sensibilidad, lo que convierte al antibiograma de disco en una herramienta visual y precisa para la interpretación de resultados.
El antibiograma de disco clasifica la respuesta bacteriana en sensible, intermedia o resistente, siguiendo estándares internacionales. Esta clasificación garantiza que el antibiograma de disco ofrezca información confiable y comparable, permitiendo a los médicos seleccionar el antibiótico más adecuado según el caso clínico del paciente.
Gracias a su metodología clara y reproducible, el antibiograma de disco sigue siendo uno de los métodos más utilizados en los laboratorios clínicos. Su funcionamiento sencillo, pero altamente efectivo, hace que el antibiograma de disco sea clave para evitar tratamientos ineficaces, reducir complicaciones y mejorar la evolución clínica de las infecciones bacterianas.
Antibiograma de disco confiable y preciso para tu diagnóstico
🧪 El antibiograma de disco es clave para elegir el antibiótico correcto y evitar resistencia bacteriana.
👉 Proteger IPS es tu mejor opción en diagnóstico clínico.
📲 Contáctenos por WhatsApp y cotiza con nosotros.

Servicios Ofrecidos por Proteger IPS
¿Cuándo se solicita un antibiograma de disco?
¿Cuándo es realmente necesario realizar esta prueba? El antibiograma de disco se solicita principalmente cuando existe una infección bacteriana confirmada o sospechada y es necesario elegir el antibiótico más eficaz. Gracias al antibiograma de disco, los médicos pueden evitar tratamientos empíricos y tomar decisiones basadas en resultados precisos de laboratorio.
El antibiograma de disco es especialmente recomendado en infecciones que no responden al tratamiento inicial. Cuando un paciente no presenta mejoría clínica, el antibiograma de disco permite identificar si la bacteria es resistente al antibiótico usado, ayudando a ajustar el tratamiento de forma oportuna y segura.
En infecciones recurrentes, el antibiograma de disco cumple un papel fundamental. Casos como infecciones urinarias repetitivas, infecciones respiratorias persistentes o infecciones de la piel requieren un antibiograma de disco para conocer con exactitud el comportamiento de la bacteria y evitar el uso repetido de antibióticos ineficaces.
El antibiograma de disco también se solicita en infecciones graves o en pacientes hospitalizados, donde un error en el tratamiento puede generar complicaciones. En estos escenarios, el antibiograma de disco aporta información clave para iniciar una terapia dirigida, reduciendo riesgos y mejorando el pronóstico del paciente.
Además, el antibiograma de disco es común en pacientes con sistemas inmunológicos debilitados, como adultos mayores o personas con enfermedades crónicas. En estos casos, el antibiograma de disco permite seleccionar el antibiótico más adecuado desde el inicio, optimizando la recuperación y disminuyendo la posibilidad de resistencia bacteriana.
¿Qué bacterias se detectan con el antibiograma de disco?
¿Sabes qué tipos de bacterias pueden identificarse con un antibiograma de disco y por qué es tan importante conocerlas?
¿Te has preguntado qué microorganismos pueden analizarse con esta prueba? El antibiograma de disco permite detectar una amplia variedad de bacterias responsables de infecciones comunes y complejas. Gracias al antibiograma de disco, es posible identificar con precisión el comportamiento de cada bacteria frente a distintos antibióticos, facilitando un tratamiento dirigido y efectivo.
El antibiograma de disco se utiliza principalmente para bacterias Gram positivas, como Staphylococcus aureus y Streptococcus, que suelen causar infecciones en la piel, vías respiratorias y tejidos blandos. Al aplicar el antibiograma de disco, los laboratorios pueden determinar rápidamente qué antibióticos son eficaces frente a este tipo de bacterias y cuáles presentan resistencia.
También, el antibiograma de disco es fundamental para el estudio de bacterias Gram negativas, como Escherichia coli, Klebsiella, Pseudomonas y Proteus. Estas bacterias están frecuentemente asociadas a infecciones urinarias, gastrointestinales y hospitalarias. El antibiograma de disco permite evaluar su nivel de sensibilidad, algo clave debido a la alta resistencia que pueden desarrollar.
En infecciones mixtas o complejas, el antibiograma de disco ayuda a identificar múltiples bacterias presentes en una misma muestra. Esto convierte al antibiograma de disco en una herramienta indispensable para establecer un tratamiento adecuado cuando existen varios microorganismos involucrados.
Además, el antibiograma de disco es ampliamente utilizado en el seguimiento de infecciones hospitalarias y comunitarias. Al conocer qué bacterias circulan y cómo responden a los antibióticos, el antibiograma de disco contribuye a mejorar las estrategias de control, prevención y tratamiento de infecciones bacterianas.
Resultados del antibiograma de disco: ¿cómo se interpretan?
¿Sabes qué significan los resultados del antibiograma de disco y cómo influyen en la elección del tratamiento?
¿Cómo saber si un antibiótico realmente funcionará? Los resultados del antibiograma de disco permiten interpretar de forma clara la respuesta de una bacteria frente a distintos antibióticos. Gracias al antibiograma de disco, los médicos pueden identificar con precisión si un medicamento será eficaz, evitando tratamientos innecesarios o ineficaces.
El antibiograma de disco clasifica los resultados en tres categorías principales: sensible, intermedio y resistente. Cuando una bacteria es sensible, el antibiograma de disco indica que el antibiótico puede eliminarla de manera efectiva a dosis habituales. Esta información es clave para iniciar un tratamiento seguro y con altas probabilidades de éxito.
Cuando el antibiograma de disco muestra una respuesta intermedia, significa que el antibiótico podría funcionar solo en ciertas condiciones, como dosis más altas o concentraciones específicas en el sitio de la infección. En estos casos, el antibiograma de disco ayuda al médico a evaluar riesgos y beneficios antes de decidir el tratamiento más adecuado.
Si el resultado del antibiograma de disco indica resistencia, el antibiótico no es efectivo contra la bacteria identificada. Esta información es fundamental, ya que el antibiograma de disco evita el uso de medicamentos que no tendrán efecto, reduciendo el riesgo de complicaciones y el avance de la resistencia bacteriana.
La correcta interpretación del antibiograma de disco permite personalizar el tratamiento según cada paciente. Al basarse en datos reales del laboratorio, el antibiograma de disco mejora la eficacia terapéutica, acorta los tiempos de recuperación y contribuye a un uso responsable de los antibióticos en la práctica médica.
¿Dónde realizar un antibiograma de disco confiable y seguro?
¿Sabes por qué elegir un laboratorio confiable marca la diferencia en los resultados del antibiograma de disco?
¿Alguna vez te has preguntado si todos los laboratorios ofrecen el mismo nivel de precisión? Realizar un antibiograma de disco en un laboratorio confiable es fundamental para garantizar resultados exactos y tratamientos efectivos. La calidad del antibiograma de disco depende directamente de los procesos, equipos y experiencia del laboratorio clínico que lo realiza.
Un antibiograma de disco confiable requiere personal capacitado, protocolos estandarizados y control de calidad constante. Cuando el antibiograma de disco se realiza bajo normas técnicas adecuadas, los resultados permiten al médico tomar decisiones acertadas y reducir el riesgo de errores en la elección del antibiótico. Por esta razón, no todos los laboratorios ofrecen el mismo nivel de seguridad diagnóstica.
Elegir un centro especializado para el antibiograma de disco también garantiza el uso de antibióticos actualizados y métodos validados internacionalmente. Esto es clave, ya que el antibiograma de disco debe reflejar con precisión los patrones reales de sensibilidad y resistencia bacteriana, especialmente en infecciones complejas o recurrentes.
Además, un laboratorio confiable asegura tiempos de entrega oportunos del antibiograma de disco, lo que impacta directamente en el inicio del tratamiento. Un antibiograma de disco entregado a tiempo permite actuar de forma rápida, evitar complicaciones y mejorar la evolución clínica del paciente.
En instituciones de salud como Proteger IPS, el antibiograma de disco se realiza con altos estándares de calidad, garantizando resultados claros, confiables y orientados a la seguridad del paciente. Contar con un antibiograma de disco bien realizado es una inversión en salud, prevención y tratamiento efectivo de las infecciones bacterianas.
Ubicanos en las Diferentes Ciudades
Nuestras sedes están estratégicamente ubicadas, Nuestro equipo esta conformado por profesionales comprometidos con tu salud, agenda tu cita es fácil. ¡Cuida de tu bienestar con Proteger IPS!
En Proteger IPS, nuestro compromiso es proporcionarle el mejor servicio posible y garantizar resultados que superen sus expectativas. Confíe en nosotros para el cuidado de tu salud y la de tus trabajadores, experimente la diferencia que ofrecemos en cada aspecto de nuestra labor.




